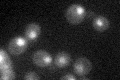

View description
Transcription factor that controls expression of ribosome biogenesis genes in response to nutrients and stress, regulates G2/M transitions during mitotic cell cycle and DNA-damage response, modulates cell size; regulated by TORC1 and Mrs6p
Localization:
Intensity:
Fold change:
Significance:
-
C’ GFP library in SD
nucleus32.73 -
N' NOP1pr-GFP in SD

nucleus59.3854 -
N' TEF2pr-mCherry in SD

nucleus38.1777 -
N' NATIVEpr-GFP in SD

nucleus19.5703 -
N' TEF2pr-VC and Cyto-VN in SD

#N/A0 -
C’ GFP library in SD+DTT

technical problem01.05No -
C’ GFP library in SD+H2O2

technical problem01.19No -
C’ GFP library in Starvation Media

cytosol34.141.04No -
C’ GFP library on the background of Pup2-DaMP

nucleus -
C’ GFP library on the background of CCT mutant

nucleus34.70531.06018No
